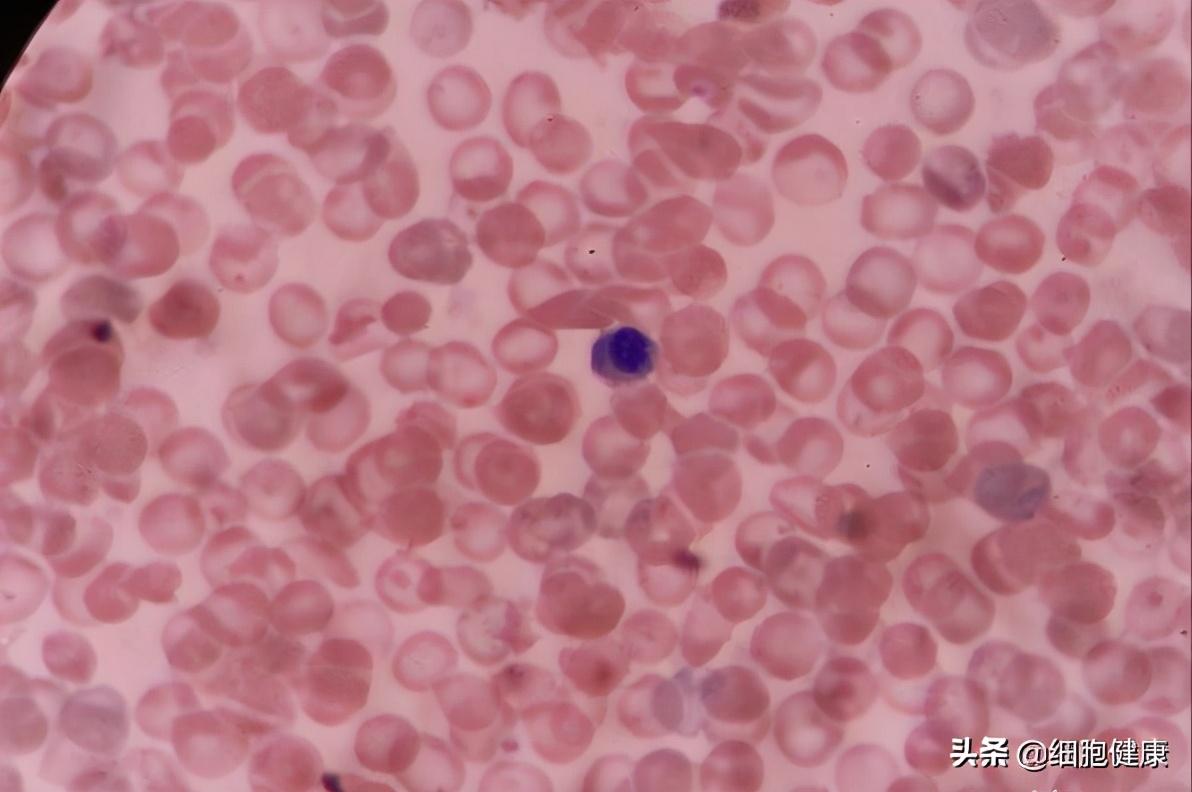

摘要:干细胞最新临床进展揭示了重塑生命科技的巨大潜力。通过干细胞治疗,多种疾病可能获得新的治疗策略。干细胞具有自我更新和分化成多种细胞类型的能力,为器官修复和再生医学领域带来革命性变化。目前,干细胞治疗在多种疾病中展现出显著效果,为临床治疗提供了新的选择。这一领域的进展不断为人类健康带来希望,展现了生命科技的无限可能。
1、产品概述
这款干细胞产品汇集了最新的生物技术成果,通过独特的干细胞分离、扩增和定向分化技术,致力于实现个性化治疗和修复人体损伤组织的目标,其独特的临床应用场景和显著的治疗效果,使这款干细胞产品成为当今生命科学领域的明星产品。
2、功能亮点
(1)高效修复:本产品能够精准地将干细胞引导至受损组织,加速组织修复,提高治疗效果。
(2)个性化治疗:结合患者的具体情况,实现干细胞的个性化治疗,大大提高治疗的安全性和有效性。
(3)广泛适应症:本产品适用于多种疾病和损伤的治疗,包括神经系统疾病、心血管疾病、骨科疾病等,为广大患者带来了福音。
(4)安全性高:本产品采用严格的质控体系和临床试验验证,确保产品的安全性和有效性。
3、使用体验
(1)便捷性:医生可以根据患者的具体情况进行个性化操作,无需复杂的手术过程,使用过程简单便捷。
(2)舒适性:治疗过程中,患者几乎不会感受到任何不适,大大减轻了治疗过程中的痛苦。
(3)高效性:治疗周期短,效果显著,患者可以在短时间内感受到身体机能的明显改善。
(4)全程关怀:产品提供全程的关怀服务,包括治疗前后的咨询、指导等,让患者无需担忧治疗过程中的任何问题,感受到温馨与关怀。
4、科技改变生活
干细胞最新临床进展为我们带来了前所未有的治疗选择,本产品以其独特的科技力量,为我们的生活带来了诸多改变,它让我们看到了生命的无限可能,让我们深切地感受到科技的力量可以战胜许多疾病和损伤。
5、激发科技爱好者的兴趣
本产品融合了最新的生物技术,展现了科技如何改变生活,激发了科技爱好者的浓厚兴趣和好奇心,它让人们对未来的医疗技术充满期待,科技爱好者们可以通过本产品深入了解最新的生物技术,探索生命的奥秘,为未来的科技发展贡献自己的力量。
6、联系方式
想了解更多关于本产品的信息,请访问我们的官方网站或拨打客服热线,我们随时为您服务,让我们一起探索生命的奥秘,为未来的健康福祉共同努力。
干细胞技术,重塑生命科技的力量,让我们一起期待更多的科技成果,为我们的生活带来更多的改变和惊喜,共同开创美好的未来!

还没有评论,来说两句吧...